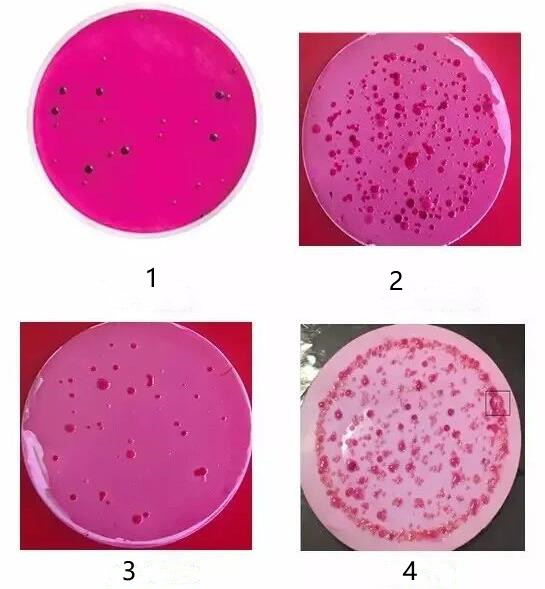

新闻详情
水质检测为什么要测总大肠菌群(水质检测时如何计总大肠菌群菌落数)-pa真人官网
作者:霍尔德电子 更新时间:2025-07-31
大家都知道,总大肠菌群是生活饮用水卫生标准中微生物指标里的一个常规检测项目。然而,一些跟“总大肠菌群”类似的名词常常把我们搞得晕头转向,对于为何要检测此项目的原因也是模糊不清,另外水质检测时怎么计总大肠菌群数量也常常让我们头疼。下面小编就这些问题找了一些资料和大家分享一下。

我们经常会听到跟“大肠”有关的微生物学或卫生学名词:总大肠菌群、大肠菌群、耐热大肠菌群、粪大肠菌群、大肠埃希氏菌、大肠杆菌、致病性大肠杆菌等等。在上述名词中,除了“大肠杆菌”和“大肠埃希氏菌”是细菌学名词以外,其余几个都是卫生细菌领域用语,它不代表某一个或某一属细菌,而是指具有某些特性的一组细菌。其中总大肠菌群=大肠菌群;耐热大肠菌群=粪大肠菌群。
水质检测时如何计总大肠菌群菌落数?使用滤膜法检测总大肠菌群的常规操作就是品红亚硫酸钠培养基培养——特征菌落镜检——乳糖蛋白胨培养液培养——计数,按照这个方法来计数是清晰明了的。但是在特殊情况下,我们没有足够的时间、人力、物力、技术去做后面的镜检和再培养,此时需要我们根据经验在第一步培养过后就做出判断。
下面通过几张图片来解说经验判断原则:
图一:图中有7个明显的紫红色含金属光泽的菌落,且其他均为颜色均匀的红色菌落。此种情况下总大肠菌群个数为7个。这种判断的准确率在90%以上。
图二:图中没有典型的紫红含金属光泽的菌落,但是有几个深红色不带金属光泽的菌落。此时需要根据之前对同一水样来源的培养情况来判断。若之前此种特征的菌落的复检阳性概率大,则应判断为阳性菌,反之亦然。
图三:图中均为颜色均匀的红色菌落,此时可全部判断为阴性。
图四:图中黑框里为一个已经产气的菌落(可看出为一个气泡),经长期镜检和再培养统计,出现产气现象的必判断为阳性。
那水质检测中为什么要检测总大肠菌群这个项目呢?总大肠菌群是作为粪便污染指标菌提出来的,主要是以该菌群的检出情况来表示水中是否有粪便污染。总大肠菌群数的高低,表明了粪便污染的程度,也反映了对人体健康危害性的大小。粪便是人类肠道排泄物,粪便内除一般正常细菌外,也会有一些肠道致病菌存在(如沙门氏菌、志贺氏菌等),因而水中有粪便污染,则可以推测该水存在着肠道致病菌污染的可能性,必须看作对人体健康具有潜在的危险性。
本文网址:https://www.codyq.net/article/236.html



